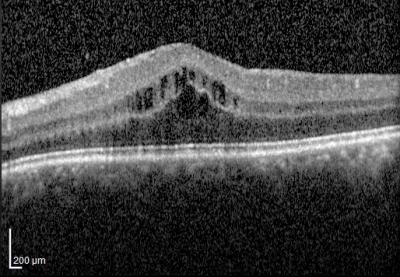
Retinal OCT showing fluid pocket in the macula

Optical coherence tomography (OCT) image showing macular edema. Image courtesy of Nisha Acharya, M.D., University of California San Francisco.
Repeat treatment with corticosteroid injections improved vision in people with persistent or recurrent uveitis-related macular edema better than two other therapies, according to results from a clinical trial funded by the National Eye Institute (NEI). Compared with methotrexate or ranibizumab intravitreal (in-the-eye) injections, the corticosteroid treatment achieved greater reductions in retinal swelling and was the only therapy in the study that improved vision. The report was published today in the journal Ophthalmology. NEI is part of the National Institutes of Health.
"Prior to this study, we didn’t know the best treatment for persistent or recurrent macular edema, a major cause of vision loss in people with uveitis," said Douglas A. Jabs, M.D., Johns Hopkins Bloomberg School of Public Health, Baltimore, chair of the study. "This trial strongly indicates that repeat intraocular corticosteroid injections are superior to either intravitreal injections of methotrexate or ranibizumab."
Uveitis is a collection of inflammatory conditions that affect the internal tissues of the eye. Uveitis can affect the front of the eye (anterior uveitis), the middle of the eye (intermediate uveitis), the back of the eye (posterior uveitis), or the front, middle, and back of the eye (panuveitis). Inflammation in the eye can lead to fluid buildup in the central part of the eye’s light-sensing retina, known as the macula, and decrease vision. This fluid buildup, called macular edema, is a complication of uveitis that often persists or recurs over time, despite uveitis treatment.
Initial treatment for uveitis-related macular edema seeks to control inflammation and reduce the fluid under the retina. While some patients achieve this goal with oral corticosteroids, most patients with macular edema also need intraocular corticosteroid injections. The dexamethasone intraocular implant is one such treatment. However, intraocular corticosteroids can raise pressure inside the eye. High intraocular pressure is a key risk factor for glaucoma, which can damage the optic nerve and lead to vision loss. Intraocular corticosteroids can also lead to cataract, a clouding of the eye’s lens, which decreases vision.

Uveitis is inflammation of the eye originating in the uvea, which includes the iris, ciliary body, and choroid.
In this study, researchers compared three treatments for uveitis-related macular edema: an additional intraocular corticosteroid injection, an injection of the anti-vascular endothelial growth factor (anti-VEGF) drug ranibizumab, or an injection of the anti-inflammatory drug methotrexate. Anti-VEGF injections are used to treat age-related macular degeneration, as well as macular edema due to other causes, such as diabetic retinopathy. Earlier, small pilot studies suggested that ranibizumab injections and the anti-inflammatory effects of methotrexate might help reduce uveitis-related macular edema.
The clinical trial enrolled 194 participants (225 study eyes) with well-controlled uveitis but persistent or recurrent macular edema. Sixty-five participants received a dexamethasone corticosteroid, 65 participants received methotrexate, and 64 participants received ranibizumab. The study took place at 33 clinical centers, located across the United States, the United Kingdom, Australia, and India. All participants had previously received at least one intravitreal corticosteroid injection for uveitis-related macular edema.
The injection schedules for each group were based on how each treatment is generally used in clinical practice. The corticosteroid group participants received one dexamethasone implant injection at baseline and, if the macular edema had not resolved, another injection at eight weeks. The methotrexate group received one injection at baseline, then repeat injections at four and eight weeks if macular edema did not resolve. The ranibizumab group received injections at baseline, four weeks, and eight weeks, even if their macular edema resolved.
After 12 weeks, all three groups showed reductions in retinal swelling. Reduction was greatest in the dexamethasone group compared to the other two (35% reduction for corticosteroid; 20% for ranibizumab; 11% for methotrexate). In addition, only the corticosteroid group showed improvement in vision, nearly five letters—about one row on an eye chart. The corticosteroid group did have more occurrences of mild increases in intraocular pressure, but rises to high levels were infrequent (<10%) in all three groups.
"Intraocular corticosteroid treatment remains the most effective therapy for uveitis-related macular edema," said Nisha Acharya, M.D., University of California San Francisco, the lead author of the study. "The vision gains in participants who received the corticosteroid treatment were very promising."
This study was funded by NEI. Allergan and Genentech provided a portion of the dexamethasone implants and ranibizumab, respectively. Clinical Trial number NCT02623426.
Reference: The Multicenter Uveitis Steroid Treatment Trial (MUST) Research Group. "Intravitreal therapy for uveitic macular edema – ranibizumab vs methotrexate vs the dexamethasone implant: The MERIT Trial Results." Ophthalmology, June 13, 2023. https://doi.org/10.1016/j.ophtha.2023.04.011
###
NEI leads the federal government’s research on the visual system and eye diseases. NEI supports basic and clinical science programs to develop sight-saving treatments and address special needs of people with vision loss. For more information, visit https://www.nei.nih.gov.
About the National Institutes of Health (NIH): NIH, the nation’s medical research agency, includes 27 Institutes and Centers and is a component of the U.S. Department of Health and Human Services. NIH is the primary federal agency conducting and supporting basic, clinical, and translational medical research, and is investigating the causes, treatments, and cures for both common and rare diseases. For more information about NIH and its programs, visit https://www.nih.gov/.
NIH…Turning Discovery Into Health®